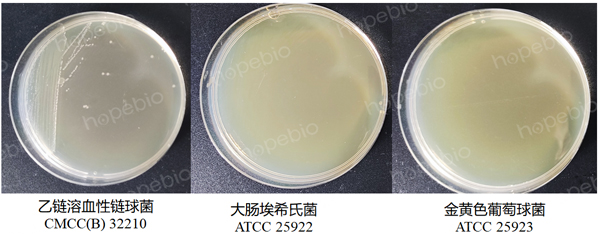

海博微信公众号
海博微信公众号
 海博天猫旗舰店
海博天猫旗舰店


 海博微信公众号
海博微信公众号
 海博天猫旗舰店
海博天猫旗舰店




一、产品介绍
主要用途:用于溶血性链球菌选择性增菌培养(GB标准)。
原理:胰酪蛋白胨、牛心浸粉和葡萄糖提供碳源、氮源、维生素和生长因子,有助于溶血性链球菌的生长;叠氮钠对革兰氏阴性细菌有抑制作用,特别对变形杆菌抑制作用明显,对革兰氏阳性菌却无抑制作用;结晶紫可以抑制某些革兰氏阳性菌生长而对链球菌无作用。
二、培养基配方(g/L)
|
胰酪蛋白胨 |
10 |
|
牛心浸粉 |
20 |
|
葡萄糖 |
0.2 |
|
叠氮钠 |
0.065 |
|
结晶紫 |
0.002 |
|
pH值7.4±0.1(25℃) |
|
三、实验方法
1、称取本品30.3g,加热溶于1000mL蒸馏水中,121℃高压灭菌15分钟,冷至50℃左右时加入脱纤维羊血50mL(1001339-1脱纤维羊血),混匀,分装于无菌试管内,每管2mL,保存于冰箱内,备用。
2、以10倍梯度稀释法制备质控菌株菌悬液,吸取适宜梯度的菌悬液加入待测培养基。
3、放置于36℃±1℃需氧培养18h-24h。
四、结果观察
接种以下质控菌株,放置36±1℃需氧培养18h-24h,培养结果如图1所示。
|
质控菌株 |
菌株编号 |
接种量(CFU) |
生长情况 |
其他特征 |
|
乙型溶血性链球菌 |
CMCC(B) 32210 |
10-100 |
+++ |
浑浊 |
|
大肠埃希氏菌 |
ATCC 25922 |
100-1000 |
— |
抑制 |
|
金黄色葡萄球菌 |
ATCC 25923 |
100-1000 |
— |
抑制 |

图1 匹克氏肉汤基础B的微生物质控结果
图2 匹克氏肉汤基础B对应试管的TSA划线结果
五、注意事项
1、培养基在加入无菌脱纤维羊血时,要注意培养基温度,避免过高或过低,以45℃-50℃为宜,可通过恒温水浴锅进行温度控制。
2、无菌脱纤维羊血产品源自羊血液制得,故保质期较短(1个月),建议在选购本产品时充分考虑试验所需用量,避免一次性过多购入导致产品超保质期失效。为保证效果稳定,尽量避免同一瓶无菌脱纤维羊血反复取用(2℃-8℃保存/恢复室温),这可能导致血液成分加速氧化、失活,也会带来更大的杂菌污染风险,无菌脱纤维羊血在出现变色后应避免再次使用。
六、相关产品展示
开云手机登录中心有相关的培养基和质控菌株,如下表所示。
|
海博生物-货号 |
名称 |
规格 |
|
HB0381 |
250g |
|
|
HBJZ058 |
支 |
|
|
HBJZ087 |
支 |
|
|
1001339-1 |
50mL |
注:本文属海博生物原创,未经允许不得转载。
下一篇:没有了!
| 相关文章: | ||



